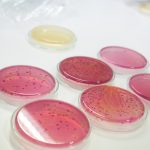

คณะเทคโนโลยีและสิ่งแวดล้อม มหาวิทยาลัยสงขลานครินทร์ วิทยาเขตภูเก็ต จัดโครงการอบรมเชิงปฏิบัติการ “TE Envi Guardians x Rotary 2026” ภายใต้ความร่วมมือกับ สโมสรโรตารีภูเก็ตเซ้าท์ ระหว่างวันที่ 4–5 เมษายน 2569 ณ มหาวิทยาลัยสงขลานครินทร์ วิทยาเขตภูเก็ต โดยมีวัตถุประสงค์เพื่อส่งเสริมความรู้และความตระหนักด้านสิ่งแวดล้อม รวมถึงพัฒนาทักษะการวิเคราะห์คุณภาพสิ่งแวดล้อมให้กับผู้เข้าร่วม
ภายในโครงการได้รับเกียรติจากวิทยากรผู้เชี่ยวชาญเป็นผู้บรรยายหลัก ได้แก่ ผู้ช่วยศาสตราจารย์ ดร.ธนิตา อารีรบ ผู้ช่วยศาสตราจารย์ ดร.ดนัย ทิพย์มณี และ ดร.สรณ์สิริ พงศ์ภัทรวัต มาร่วมถ่ายทอดความรู้ทั้งภาคทฤษฎีและภาคปฏิบัติ
กิจกรรมในวันแรกประกอบด้วยการบรรยายในหัวข้อการตรวจวัดคุณภาพน้ำที่มีผลต่อสิ่งแวดล้อมและสุขภาพมนุษย์ การเก็บตัวอย่างน้ำ และการวิเคราะห์ค่าพารามิเตอร์คุณภาพน้ำ พร้อมทั้งการลงพื้นที่ภาคสนามเพื่อเก็บตัวอย่างน้ำจริง นอกจากนี้ยังมีกิจกรรม Workshop การวิเคราะห์จุลินทรีย์ในน้ำ และการวิเคราะห์ออกซิเจนละลายในน้ำ
ในวันที่สอง ผู้เข้าร่วมจะได้ฝึกปฏิบัติในหัวข้อการวิเคราะห์แอมโมเนียไนโตรเจนในน้ำ การวิเคราะห์จุลินทรีย์เพิ่มเติม ตลอดจนการสรุปผล อภิปราย และนำเสนอผลการวิเคราะห์คุณภาพน้ำจากกิจกรรมที่ได้ดำเนินการ
โครงการดังกล่าวมุ่งเน้นให้ผู้เข้าร่วมได้รับทั้งความรู้เชิงวิชาการและประสบการณ์จริง เพื่อสามารถนำไปประยุกต์ใช้ในการอนุรักษ์และจัดการทรัพยากรสิ่งแวดล้อมได้อย่างมีประสิทธิภาพและยั่งยืน

Leave a Reply